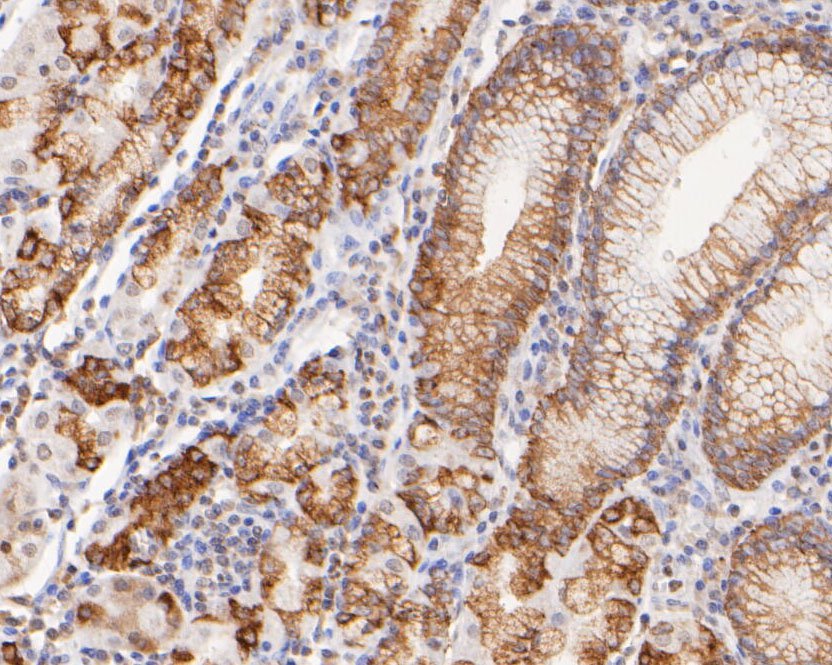
Fig3:; Immunohistochemical analysis of paraffin-embedded human Stomach tissue using anti-FAT1 antibody. The section was pre-treated using heat mediated antigen retrieval with sodium citrate buffer (pH 6.0) for 20 minutes. The tissues were blocked in 5% BSA for 30 minutes at room temperature, washed with ddH; 2; O and PBS, and then probed with the primary antibody ( 1/100) for 1 hour at room temperature. The detection was performed using an HRP conjugated compact polymer system. DAB was used as the chromogen. Tissues were counterstained with hematoxylin and mounted with DPX.

-
Product Name
Anti-FAT1 antibody
- Documents
-
Description
Rabbit polyclonal antibody to FAT1
-
Tested applications
WB, IHC-P
-
Species reactivity
Human
-
Alternative names
FAT antibody; ME5 antibody; CDHF7 antibody; CDHR8 antibody; hFat1 antibody
-
Isotype
Rabbit IgG
-
Preparation
This antigen of this antibody was synthetic peptide within human protocadherin fat 1 aa 238-287 / 4,588.
-
Clonality
Polyclonal
-
Formulation
Liquid, 1*TBS (pH7.4), 0.2% BSA, 50% Glycerol. Preservative: 0.05% Sodium Azide.
-
Storage instructions
Store at +4℃ after thawing. Aliquot store at -20℃ or -80℃. Avoid repeated freeze / thaw cycles.
-
Applications
WB: 1:2,000-5,000
IHC-P: 1:100-1:400
-
Validations

Fig1:; Western blot analysis on Fat1 recombinant protein at 1:5,000.

Fig2:; Immunohistochemical analysis of paraffin-embedded human Colon cancer tissue using anti-FAT1 antibody. The section was pre-treated using heat mediated antigen retrieval with sodium citrate buffer (pH 6.0) for 20 minutes. The tissues were blocked in 5% BSA for 30 minutes at room temperature, washed with ddH; 2; O and PBS, and then probed with the primary antibody ( 1/100) for 1 hour at room temperature. The detection was performed using an HRP conjugated compact polymer system. DAB was used as the chromogen. Tissues were counterstained with hematoxylin and mounted with DPX.
Fig3:; Immunohistochemical analysis of paraffin-embedded human Stomach tissue using anti-FAT1 antibody. The section was pre-treated using heat mediated antigen retrieval with sodium citrate buffer (pH 6.0) for 20 minutes. The tissues were blocked in 5% BSA for 30 minutes at room temperature, washed with ddH; 2; O and PBS, and then probed with the primary antibody ( 1/100) for 1 hour at room temperature. The detection was performed using an HRP conjugated compact polymer system. DAB was used as the chromogen. Tissues were counterstained with hematoxylin and mounted with DPX.
- Background
-
References
- Molecular cloning and tissue expression of FAT, the human homologue of the Drosophila fat gene that is located on chromosome 4q34-q35 and encodes a putative adhesion molecule.Dunne J., Hanby A.M., Poulsom R., Jones T.A., Sheer D., Chin W.G., Da S.M., Zhao Q., Beverley P.C.L., Owen M.J.Genomics 30:207-223(1995)
- Protocadherin FAT1 binds Ena/VASP proteins and is necessary for actin dynamics and cell polarization Marcus J Moeller, Abdulsalam Soofi, Gerald S Braun1, Xiaodong Li, Carsten Watzl2, Wilhelm Kriz1 and Lawrence B Holzman. The EMBO Journal 23:3769-3779(2004)
Related Products / Services
Please note: All products are "FOR RESEARCH USE ONLY AND ARE NOT INTENDED FOR DIAGNOSTIC OR THERAPEUTIC USE"
